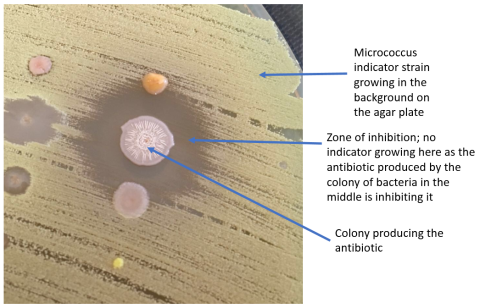

Getting citizen scientists in the zone with drug discovery
Drug resistance is a major challenge to healthcare systems across the world.
Resistance results in longer hospital stays, increased economic burden and higher morbidity and mortality due to infectious disease. It will only be addressed with huge efforts on multiple fronts, including improved and sustained stewardship of current and future antimicrobials, the development of antibiotic alternatives and rapid diagnostics.
Addressing resistance

However, due to the inevitability of the evolution of resistance, the main way we will be able to alleviate its symptoms within our healthcare systems is with new drugs.
The vast majority of antibiotics we currently use are natural products of bacteria or fungi. They make these products to give themselves a competitive advantage in their natural habitat. This is what Alexander Fleming noticed on his agar plate on the morning of Friday 28 September 1928 in London, an observation which ultimately led to the first industrial scale use of any antibiotic: penicillin.
The urgent need for new antibiotics is now well-recognised, but the current and unsuitable economic model (for profit) for research and development in this area means activity is not nearly as intensive as it could or should be. Funding for the early-stage discovery of new antibiotics is hard to secure because it is an inherently risky investment i.e. the chances of success are really low.
Despite the lack of funding and the unlikelihood of success, many conversations with funders, colleagues, teachers and members of the public convinced me of an untapped enthusiasm for small scale research in drug discovery within the general public.
Positive public engagement
It was also clear that this “positive” type of project lends itself especially well to public engagement, particularly in an area traditionally dominated by stories of doom, gloom and the seemingly inevitable post-antibiotic apocalyptic world, to which I myself have suggested we are heading.
Combining all the above into a coherent project with a chance of success was tricky but, in the early part of 2015, I launched Swab and Send. It’s a citizen science, crowd-funded, drug-discovery project aimed at engaging the public with the issues surrounding drug resistance and the difficulties in searching for new antibiotics.
Swab and Send allows citizen scientists, who pledge a small amount of money to cover laboratory consumables, to decide where to look for microbes which may produce antibiotics, by carrying out the initial sampling themselves. Participants receive swabs and decide where, what, or in some cases, who to sample.
A host of imaginative, weird and wonderful places and things have been swabbed from as far afield as Canada and Egypt and by an enormous collective of independent participants, families, schools, colleges, societies and commercial enterprises.
Dead bald eagles, Jeremy Bentham's preserved head and goo

We’ve already had well over a thousand people take part – from toddlers to older people. We can’t actually be sure of the actual number, however, as some events send over 100 swabs back and some only single swabs, while one participant may give as many as ten swabs.
The list of where the swabs come from is as enormous, as it is weird: dead bald eagles, various poo, cars, buses trains, all parts of the human body including teeth, hair, feet and lady garden, various pets and wild animals, everything in and around a house and garden, university libraries, the Alexander Fleming Museum, Jeremy Bentham’s preserved head, the SS Great Britain, Isambard Kingdom Brunel’s cigar, stone circles, a myriad of unidentifiable goo from a range of places, Westminster, research council CEO desks, spider webs – it just goes on and on.
The swabs are returned to our laboratories at the LSTM where we grow everything we can on agar plates. We have grown a wonderful variety of microbes, some of which we have never seen before.
We purify the cultures and use these microbes in our simple microbiological tests to see if they are able to inhibit the growth of a range of indicator microbes in much the same way as Fleming did all those years ago.
Our indicators include the same strain of Micrococcus luteus that Alexander Fleming used, plus a host of other clinically important strains, such methicillin resistant Staphylococcus aureus (MRSA), multi-drug resistant Escherichia coli and the pathogenic fungi Candida albicans and Candida auris.
In the zone
All results are photographed and posted on the project website. If we get a “hit”; meaning a microbe from a swab which can prevent the growth of our indicator microbes, evidenced by a “zone of inhibition” (see image) around the producing colony, then we can pursue that strain with conventional scientific research to try and determine what it is, what it is producing and if it is suitable for use in human or veterinary medicine. We are currently following some extremely promising leads that can inhibit the growth of E. coli and C. albicans.
The project has hugely exceeded my expectations, which is testament to the enthusiasm of the public, educators and students when it comes to participation in scientific research.
Feedback from participants shows that it has educated and clarified individual perceptions of drug resistance, helped to de-mystify scientific research and deconstruct perceived barriers to careers in science.
Children have expressed surprise that they are able to participate in projects that “real” scientists are carrying out. Breaking down these barriers is a key step in encouraging school children worldwide to take up STEM subjects.
Get involved
It also develops the idea of scientific citizenship, something which cements the activities of scientists within the everyday lives of individuals who participate, and within their society. This is important because, after all, we all have our own part to play in the control of drug resistance. If we are lucky enough to find a new, medically useful compound as part of Swab and Send, we will hopefully all benefit.
If you’re interested in finding out more about Swab and Send or want to discuss taking part in the project, visit the Swab and Send website.
Contact Adam
Follow Adam on Twitter